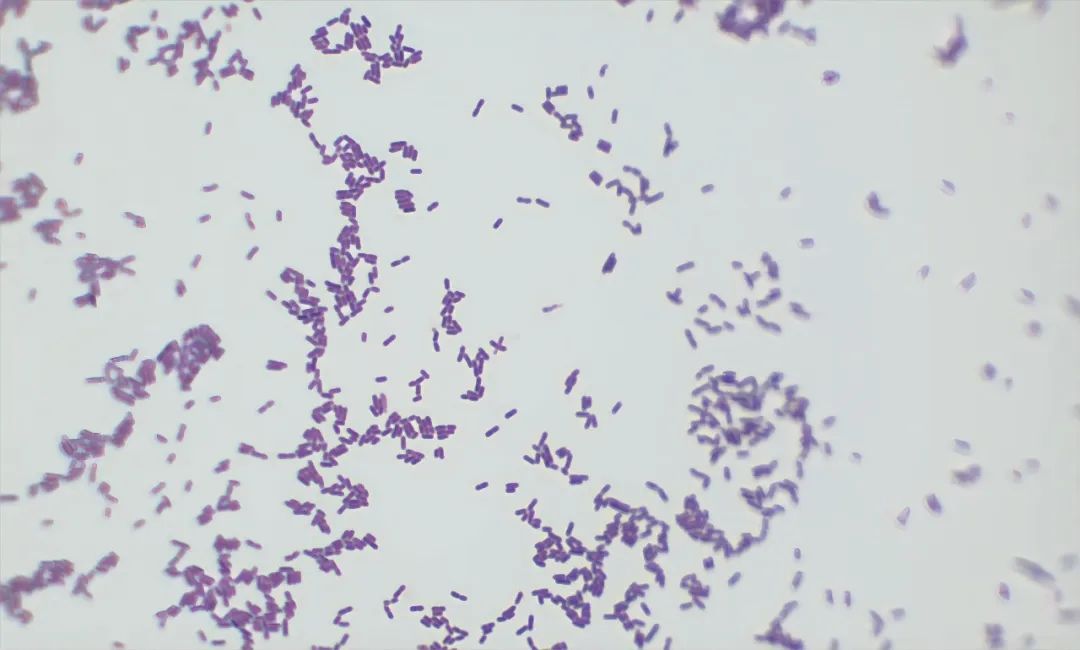
专挑宝宝、孕妇和老人下手!这种致病菌可能就藏在冰箱里 专挑宝宝、孕妇和老人下手!这种致病菌可能就藏在冰箱里

近期,河南省疾病预防控制中心通过食源性疾病监测数据发现,多起准妈妈、婴幼儿和老人因感染单核细胞增生李斯特氏菌引起败血症、脑膜炎,甚至流产和胎儿死亡的病例。
最终流调发现,这些病例均与冰箱有关。
单增李斯特菌的“冷酷”特性
单增李斯特菌是一种革兰氏阳性菌,能在低温环境下生长,在2℃至42℃的温度范围内都能生长,甚至在-20℃的冷冻室里也能存活一年。
这意味着,我们家中常用的冰箱冷藏室温度(0℃至10℃)恰好是它繁殖的“温床”。因此,未加热透的冷藏食品,尤其是乳制品、肉制品和水产品,都可能成为传播这种细菌的媒介。
显微镜下的单增李斯特菌
图源:河南疾控
这种细菌不仅生命力顽强,而且其感染对象广泛,尤其对孕妇、婴幼儿和老人构成严重威胁。
对各类人群的危害
1.对孕妇的危害
感染这种细菌后,孕妇可能会出现低热、恶心、腹泻等症状,这些症状看似轻微,但可能对胎儿造成严重影响。
妊娠早期,感染可能导致胎儿停止生长;
妊娠晚期,则可能引发死胎、流产或早产。
此外,孕妇感染单增李斯特菌后,还可能通过胎盘或产道将细菌传递给新生儿,导致新生儿败血症、脑膜炎等严重后果。
2.对婴幼儿和老人的威胁
对于新生儿和免疫系统尚未发育完全的婴幼儿来说,感染这种细菌会出现败血症、肺炎等症状,严重时甚至可能危及生命。
对于老年人来说,由于免疫系统和器官功能逐渐衰退,他们感染单增李斯特菌后更容易发展成严重的血液感染(败血症)或脑部感染(脑膜炎)。
如何预防单增李斯特菌感染?
1.冷藏食品加热食用:从冰箱取出的食品一定要加热至70℃以上,加热持续5~20分钟就可以杀死单增李斯特菌。
2.注意食品储存:蔬果等食物在放入冰箱冷藏前应先擦拭干净,避免交叉污染。75%的酒精可以杀灭食品包装上的单增李斯特菌。同时,生食与熟食应分区域存放。
3.定期清洁冰箱:经常对冰箱内壁进行清洁,防止细菌滋生。要先将冰箱内食物取出,用洗洁精擦拭后,再用清水擦干净,晾干或用厨房纸擦干。
4.免疫力较低人群慎食:老人、孕妇、婴幼儿等免疫力较低的人群应少吃或不吃冷藏食品,最好现做现吃。
5.当怀疑感染单增李斯特菌时应及时就医。
让我们共同警惕这个“冰箱杀手”,守护家人的健康!
转自河南疾控
来源: 大河网